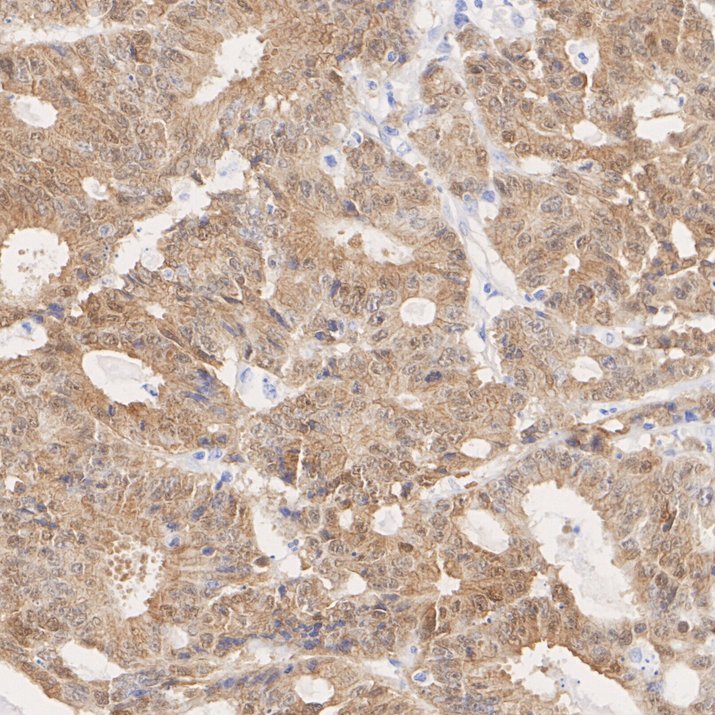
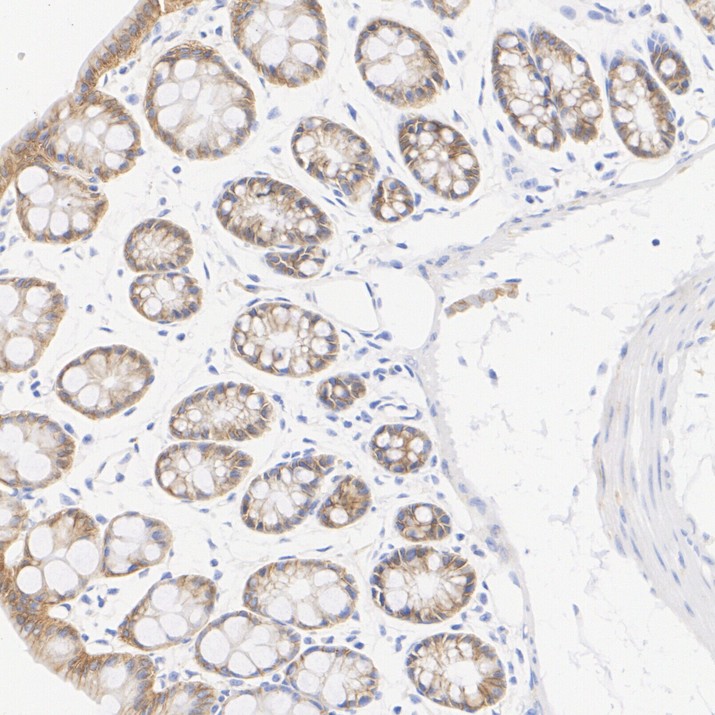

Beta Catenin Recombinant Antibody - Rat IgG1 (Chimeric) - BSA and Azide free
Rmb: 5600 特惠
产品规格
Catalog# HA610385
Beta Catenin Recombinant Antibody - Rat IgG1 (Chimeric) - BSA and Azide free
-
WB
-
IHC-Fr
-
IHC-P
-
IF-Cell
-
mIHC
-
Human
-
Mouse
-
Rat
-
HA601570
含抗保成分
-
unconjugated
Safety datasheet
概述
产品名称
Beta Catenin Recombinant Antibody - Rat IgG1 (Chimeric) - BSA and Azide free
抗体类型
Recombinant Chimeric Antibody
免疫原
Synthetic peptide within human Beta-Catenin aa 30-70.
种属反应性
Human, Mouse, Rat
验证应用
WB, IHC-Fr, IHC-P, IF-Cell, mIHC
分子量
Predicted band size: 85 kDa
阳性对照
HeLa cell lysate, NIH/3T3 cell lysate, C6 cell lysate, Mouse brain tissue lysate, Rat brain tissue lysate, human colon cancer tissue, human colon tissue, mouse colon tissue, rat colon tissue, C6.
偶联
unconjugated
克隆号
SA30-04
产品特性
形态
Liquid
浓度
存放说明
Store at +4℃ after thawing. Aliquot store at -20℃. Avoid repeated freeze / thaw cycles.
存储缓冲液
1*PBS (pH7.4).
纯化方式
Protein A affinity purified.
应用稀释度
-
WB
-
1:2,000-1:5,000
-
IHC-Fr
-
1:200
-
IHC-P
-
1:200-1:1,000
-
IF-Cell
-
1:100
-
mIHC
-
1:1,000
靶点
功能
Catenin beta-1, also known as beta-catenin (β-catenin), is a protein that in humans is encoded by the CTNNB1 gene. Beta-catenin is a dual function protein, involved in regulation and coordination of cell–cell adhesion and gene transcription. In humans, the CTNNB1 protein is encoded by the CTNNB1 gene. In Drosophila, the homologous protein is called armadillo. β-catenin is a subunit of the cadherin protein complex and acts as an intracellular signal transducer in the Wnt signaling pathway. Mutations and overexpression of β-catenin are associated with many cancers, including hepatocellular carcinoma, colorectal carcinoma, lung cancer, malignant breast tumors, ovarian and endometrial cancer. Alterations in the localization and expression levels of beta-catenin have been associated with various forms of heart disease, including dilated cardiomyopathy. β-catenin is regulated and destroyed by the beta-catenin destruction complex, and in particular by the adenomatous polyposis coli (APC) protein, encoded by the tumour-suppressing APC gene. Therefore, genetic mutation of the APC gene is also strongly linked to cancers, and in particular colorectal cancer resulting from familial adenomatous polyposis (FAP).
背景文献
1. Liu J et al. Wnt/beta-catenin signalling: function, biological mechanisms, and therapeutic opportunities. Signal Transduct Target Ther. 2022 Jan
2. Yu F et al. Wnt/beta-catenin signaling in cancers and targeted therapies. Signal Transduct Target Ther. 2021 Aug
亚细胞定位
Cytoplasm, Nucleus, Cell membrane, Cell junction
别名
β Catenin
Beta catenin antibody
Beta-catenin antibody
Cadherin associated protein antibody
Catenin (cadherin associated protein), beta 1, 88kDa antibody
Catenin beta 1 antibody
Catenin beta-1 antibody
CATNB antibody
CHBCAT antibody
CTNB1_HUMAN antibody
展开β Catenin
Beta catenin antibody
Beta-catenin antibody
Cadherin associated protein antibody
Catenin (cadherin associated protein), beta 1, 88kDa antibody
Catenin beta 1 antibody
Catenin beta-1 antibody
CATNB antibody
CHBCAT antibody
CTNB1_HUMAN antibody
CTNNB antibody
CTNNB1 antibody
DKFZp686D02253 antibody
FLJ25606 antibody
FLJ37923 antibody
OTTHUMP00000162082 antibody
OTTHUMP00000165222 antibody
OTTHUMP00000165223 antibody
OTTHUMP00000209288 antibody
OTTHUMP00000209289 antibody
折叠图片
-

Western blot analysis of Beta Catenin on different lysates with Rat anti-Beta Catenin antibody (HA610385) at 1/5,000 dilution.
Lane 1: HeLa cell lysate (20 µg/Lane)
Lane 2: NIH/3T3 cell lysate (20 µg/Lane)
Lane 3: C6 cell lysate (20 µg/Lane)
Lane 4: Mouse brain tissue lysate (40 µg/Lane)
Lane 5: Rat brain tissue lysate (40 µg/Lane)
Predicted band size: 85 kDa
Observed band size: 85 kDa
Exposure time: 3 minutes; ECL: K1801;
4-20% SDS-PAGE gel.
Proteins were transferred to a PVDF membrane and blocked with 5% NFDM/TBST for 1 hour at room temperature. The primary antibody (HA610385) at 1/5,000 dilution was used in primary antibody dilution (K1803) at 4℃ overnight. Goat Anti-Rat IgG H&L - HRP Secondary Antibody (HA1023) at 1/50,000 dilution was used for 1 hour at room temperature. -

Application: IHC-Fr
Species: Mouse
Site: colon
Sample: Frozen section
Antibody concentration: 1/200
Antigen retrieval: Not required -
Immunohistochemical analysis of paraffin-embedded human colon cancer tissue with Rat anti-Beta Catenin antibody (HA610385) at 1/1,000 dilution.
The section was pre-treated using heat mediated antigen retrieval with Tris-EDTA buffer (pH 9.0) for 20 minutes. The tissues were blocked in 1% BSA for 20 minutes at room temperature, washed with ddH2O and PBS, and then probed with the primary antibody (HA610385) at 1/1,000 dilution for 1 hour at room temperature. The detection was performed using an HRP conjugated compact polymer system. DAB was used as the chromogen. Tissues were counterstained with hematoxylin and mounted with DPX. -

Immunohistochemical analysis of paraffin-embedded human colon tissue with Rat anti-Beta Catenin antibody (HA610385) at 1/200 dilution.
The section was pre-treated using heat mediated antigen retrieval with Tris-EDTA buffer (pH 9.0) for 20 minutes. The tissues were blocked in 1% BSA for 20 minutes at room temperature, washed with ddH2O and PBS, and then probed with the primary antibody (HA610385) at 1/200 dilution for 1 hour at room temperature. The detection was performed using an HRP conjugated compact polymer system. DAB was used as the chromogen. Tissues were counterstained with hematoxylin and mounted with DPX. -
Immunohistochemical analysis of paraffin-embedded mouse colon tissue with Rat anti-Beta Catenin antibody (HA610385) at 1/1,000 dilution.
The section was pre-treated using heat mediated antigen retrieval with Tris-EDTA buffer (pH 9.0) for 20 minutes. The tissues were blocked in 1% BSA for 20 minutes at room temperature, washed with ddH2O and PBS, and then probed with the primary antibody (HA610385) at 1/1,000 dilution for 1 hour at room temperature. The detection was performed using an HRP conjugated compact polymer system. DAB was used as the chromogen. Tissues were counterstained with hematoxylin and mounted with DPX. -

Immunohistochemical analysis of paraffin-embedded rat colon tissue with Rat anti-Beta Catenin antibody (HA610385) at 1/1,000 dilution.
The section was pre-treated using heat mediated antigen retrieval with Tris-EDTA buffer (pH 9.0) for 20 minutes. The tissues were blocked in 1% BSA for 20 minutes at room temperature, washed with ddH2O and PBS, and then probed with the primary antibody (HA610385) at 1/1,000 dilution for 1 hour at room temperature. The detection was performed using an HRP conjugated compact polymer system. DAB was used as the chromogen. Tissues were counterstained with hematoxylin and mounted with DPX. -

Immunocytochemistry analysis of C6 cells labeling Beta Catenin with Rat anti-Beta Catenin antibody (HA610385) at 1/100 dilution.
Cells were fixed in 4% paraformaldehyde for 15 minutes at room temperature, permeabilized with 0.1% Triton X-100 in PBS for 15 minutes at room temperature, then blocked with 1% BSA in 10% negative goat serum for 1 hour at room temperature. Cells were then incubated with Rat anti-Beta Catenin antibody (HA610385) at 1/100 dilution in 1% BSA in PBST overnight at 4 ℃. Goat Anti-Rat IgG H&L (iFluor™ 488, HA1133) was used as the secondary antibody at 1/1,000 dilution. PBS instead of the primary antibody was used as the secondary antibody only control. Nuclear DNA was labelled in blue with DAPI.
Beta tubulin (HA601187, red) was stained at 1/100 dilution overnight at +4℃. Goat Anti-Mouse IgG H&L (iFluor™ 594, HA1126) was used as the secondary antibody at 1/1,000 dilution.
请注意: All products are "FOR RESEARCH USE ONLY AND ARE NOT INTENDED FOR DIAGNOSTIC OR THERAPEUTIC USE"
同靶点 & 同通路的产品
Beta Catenin Recombinant Antibody - Rat IgG1 (Chimeric)
Application: mIHC
Reactivity: Human
Conjugate: unconjugated
Beta Catenin Mouse Monoclonal Antibody [10-C0-B7]
Application: WB,IF-Cell,IHC-P,FC
Reactivity: Human,Mouse,Rat
Conjugate: unconjugated
Beta Catenin Recombinant Antibody - Rat IgG1 (Chimeric)
Application: WB,IHC-Fr,IHC-P,IF-Cell,mIHC
Reactivity: Human,Mouse,Rat
Conjugate: unconjugated
Phospho-Beta Catenin (S552) Recombinant Rabbit Monoclonal Antibody [PSH08-72]
Application: WB,IF-Cell,IHC-P,FC
Reactivity: Human,Mouse,Rat
Conjugate: unconjugated
Phospho-Beta Catenin (T41/S45) Recombinant Rabbit Monoclonal Antibody [JE54-02]
Application: WB,IHC-P
Reactivity: Human,Mouse,Rat
Conjugate: unconjugated
Beta Catenin Mouse Monoclonal Antibody [A6-F8]
Application: WB,IF-Cell,IHC-P,FC,IF-Tissue,ChIP
Reactivity: Human,Mouse,Rat
Conjugate: unconjugated
Beta Catenin Recombinant Rabbit Monoclonal Antibody [SA30-04] - BSA and Azide free
Application: WB,IHC-P,IF-Tissue,IP,IF-Cell,IHC-Fr,FC
Reactivity: Human,Mouse,Rat
Conjugate: unconjugated
Phospho-Beta Catenin (S552) Recombinant Rabbit Monoclonal Antibody [PSH08-72] - BSA and Azide free
Application: WB,IF-Cell,IHC-P,FC
Reactivity: Human,Mouse,Rat
Conjugate: unconjugated
Beta Catenin Rabbit Polyclonal Antibody
Application: WB,IF-Cell
Reactivity: Human,Mouse,Rat,Zebrafish
Conjugate: unconjugated
Beta Catenin Recombinant Mouse Monoclonal Antibody [A6-F8-R] - BSA and Azide free
Application: WB,IF-Cell,IHC-P,FC
Reactivity: Human,Mouse,Rat
Conjugate: unconjugated
Beta Catenin Recombinant Rabbit Monoclonal Antibody [SA30-04]
Application: WB,IHC-P,IF-Tissue,IP,mIHC,IF-Cell,IHC-Fr,FC
Reactivity: Human,Mouse,Rat
Conjugate: unconjugated
Beta Catenin Recombinant Antibody - Mouse IgG1 (Chimeric)
Application: mIHC
Reactivity: Human
Conjugate: unconjugated
Beta Catenin Rabbit Polyclonal Antibody
Application: WB,IHC-P,FC,IF-Cell,IF-Tissue
Reactivity: Human,Mouse,Rat
Conjugate: unconjugated
Phospho-Beta Catenin (S33 + S37) Recombinant Rabbit Monoclonal Antibody [JE59-59]
Application: WB
Reactivity: Human,Rat,Mouse
Conjugate: unconjugated
iFluor™ 488 Conjugated Beta Catenin Recombinant Rabbit Monoclonal Antibody [SA30-04]
Application: IF-Tissue,IF-Cell
Reactivity: Human,Mouse
Conjugate: iFluor™ 488
Beta Catenin Recombinant Mouse Monoclonal Antibody [A6-F8-R]
Application: WB,IF-Cell,IHC-P,FC
Reactivity: Human,Mouse,Rat
Conjugate: unconjugated
Beta Catenin Recombinant Rabbit Monoclonal Antibody
Application: mIHC
Reactivity: Human
Conjugate: unconjugated



















 浙公网安备 33019202000643号
浙公网安备 33019202000643号